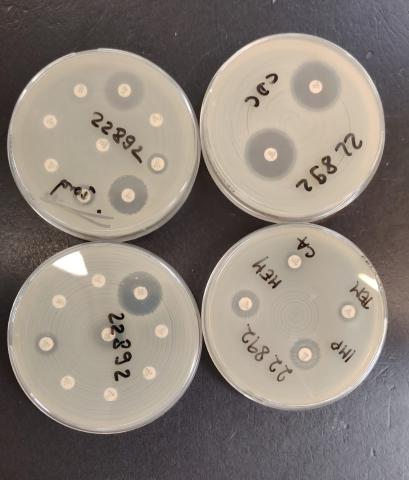
bakterije

NOVOSTI26.02.2026.
Jučer smo ugostili učenike i nastavnike Srednje škole Buzet i Srednje škole Čakovec, polaznike predmeta Škola i zajednica, koji se ove školske godine bave temom uvođenja predmeta Zdravstveni odgoj u škole Istarske županije i Grada Čakovca.
NOVOSTI27.01.2026.
Upis u školu uzbudljivo je razdoblje za dijete, ali i za roditelje. Većina se roditelja pita kako pripremiti dijete za pregled, kako sam pregled izgleda, koje je administrativne korake potrebno obaviti te na koji se način naručiti.
NOVOSTI10.03.2026.
Projekti
Vaše zdravlje
VIDI VIŠEKutak za roditelje25.09.2025.
„Neću ga previše hvaliti, da se ne pokvari“ ili „Tko se hvali, taj se kvari“ moto je određenog broja roditelja koji su uvjereni u istinitost ovih izreka. Ponekad i pohvale svoju djecu pred drugima, ali „oči u oči“ gotovo nikad.
Mentalno zdravlje25.09.2025.
Početak rujna za mnoge znači povratak na posao nakon ljetnog odmora. Iako povratak u rutinu može biti koristan, brojni zaposlenici se suočavaju sa stresom, umorom i padom motivacije, što može negativno utjecati na njihovu produktivnost i opće zadovoljstvo.
Jeste li znali?20.01.2026.
COVID-1909.10.2025.
Mentalno zdravlje14.06.2024.
Edukacije15.02.2022.
Usluge
Paragraph

![Istraživački projekt RESPIVIRUS [IP-2016-06-7556]](/sites/default/files/styles/large/public/2021-07/profimedia-0353298806.jpg?itok=yfkB8PUt)



